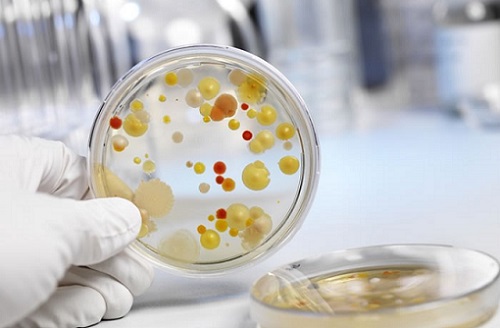
посев

Причины грибкового поражения слизистой пищевода
Микроорганизмы начинают паразитировать, когда для этого создаются подходящие условия.
Грибковый эзофагит и факторы, способствующие его развитию:
- Длительное применение медикаментов, таких как антибиотики, гормоны, химиотерапевтические препараты, иммунодепрессанты и антигистамины.
- Серьезные заболевания внутренних органов ─ диабет первого типа, СПИД, болезни эндокринной системы, онкология.
- Хронические заболевания с рецидивами.
- Физиологические состояния ─ беременность, старческий или младенческий возраст.
- Рефлюкс ─ обратное движение содержимого желудка в пищевод.
- Травмы и хирургические операции.
- Употребление алкоголя и курение.
- Токсическое воздействие на слизистую оболочку.
Врачи отмечают, что кандидозный эзофагит является серьезным заболеванием, вызванным грибами рода Candida. Это состояние чаще всего встречается у пациентов с ослабленным иммунитетом, таких как люди с ВИЧ, диабетом или после химиотерапии. Симптомы включают боль при глотании, дискомфорт в груди и иногда лихорадку. Специалисты подчеркивают важность ранней диагностики и лечения, так как запущенные случаи могут привести к серьезным осложнениям. Антифунгальные препараты, такие как флуконазол, часто используются для терапии, однако врачи также рекомендуют уделять внимание профилактике, включая поддержание нормального уровня иммунной функции и соблюдение гигиенических норм. В целом, комплексный подход к лечению и профилактике кандидозного эзофагита является ключевым для успешного восстановления пациентов.

Признаки заболевания
Основные признаки заболевания включают белый или светло-желтый налет на слизистой оболочке пищевода, а также болезненные ощущения, усиливающиеся при глотании. Дискомфорт может распространяться на ротовую полость, создавая ощущение наличия инородного тела в горле. Кроме того, неприятные ощущения могут возникать в области эпигастрия.
У пациента могут наблюдаться следующие симптомы:
- изжога,
- отрыжка,
- тошнота,
- повышенное выделение слюны,
- рвота.
На начальном этапе кандидозный эзофагит проявляется в остром виде, который характеризуется грибковым поражением нижней части пищевода. Симптоматика развивается быстро на фоне высокой температуры.
Если лечение не будет адекватным, заболевание может перейти в хроническую стадию, когда ремиссии и обострения будут чередоваться. При хроническом течении болезни происходят структурные изменения слизистой пищевода, такие как язвы, эрозии, предраковое состояние и прободение стенок с последующим кровотечением.
Особенности грибкового воспаления пищевода у детей включают:
- усиление болей при употреблении пищи с контрастной температурой (горячей или холодной), во время сна и при физической активности;
- ощущение тяжести в области живота;
- у грудных детей — плохой сон, срыгивания, потерю веса и замедленный рост.
| Категория | Описание | Рекомендации |
|---|---|---|
| Причины и факторы риска | Ослабленный иммунитет (ВИЧ, онкология, трансплантация органов), длительный прием антибиотиков, кортикостероидов, сахарный диабет, пожилой возраст, гастроэзофагеальная рефлюксная болезнь (ГЭРБ). | Контроль основного заболевания, избегание необоснованного приема антибиотиков, поддержание гигиены полости рта. |
| Симптомы | Затрудненное и болезненное глотание (одинофагия, дисфагия), боль за грудиной, изжога, тошнота, рвота, потеря аппетита, белый налет на языке и слизистой рта. | При появлении симптомов немедленно обратиться к врачу для диагностики и лечения. |
| Диагностика | Эндоскопия с биопсией и микроскопией, посев биоптата на грибы, рентгенография пищевода с контрастом. | Своевременная диагностика позволяет начать адекватное лечение и предотвратить осложнения. |
| Лечение | Противогрибковые препараты (флуконазол, итраконазол, вориконазол) системного или местного действия, в зависимости от тяжести и распространенности процесса. | Строгое соблюдение дозировки и длительности курса лечения, назначенного врачом. |
| Профилактика | Поддержание иммунитета, контроль хронических заболеваний, рациональное использование антибиотиков, соблюдение гигиены полости рта, избегание раздражающей пищи. | Регулярные медицинские осмотры, особенно для групп риска. |
Диагностика и медикаментозное лечение
Кандидозный эзофагит легко диагностируется. Для этого пациенту проводят эндоскопическое обследование глотки, пищевода и желудка. На основании полученных данных врач может установить предварительный диагноз.
Для подтверждения диагноза выполняется лабораторное исследование мазка — посев, который позволяет определить вид грибка. Однако этот метод имеет свои недостатки: результаты могут быть искажены, если пациент принимает антибиотики, противогрибковые препараты или алкоголь.
ПЦР (полимеразная цепная реакция) — это иммунологический метод, который обеспечивает наиболее точные результаты. Он позволяет точно выявить наличие микроорганизмов и распознать хроническую форму заболевания.
Лечение кандидозного эзофагита направлено на подавление грибковой активности. В этом случае пациентам назначают противогрибковые средства:
- Флуконазол;
- Миконазол;
- Клотримазол.
Сложности в лечении кандидозного эзофагита возникают на фоне тяжелого иммунодефицита и низкого уровня лейкоцитов. В таких случаях необходимо не только проводить антигрибковую терапию, но и восстанавливать уровень нейтрофильных лейкоцитов, которые играют ключевую роль в защите от Candida. Для улучшения иммунной функции эндоскопически вводят концентрат гранулоцитов в сочетании с интенсивным лазерным облучением, что способствует ускорению фагоцитоза.
Если симптомы кандидозного эзофагита выражены, лечение сосредоточено на их устранении. Пациентам назначаются:
- Жаропонижающие средства — Парацетамол, Ибупрофен;
- Обезболивающие — Но-шпа, Баралгин, Спазмалгон, Диклофенак, Кетанов;
- Обволакивающие препараты — Альмагель, Фосфалюгель, Де-Нол.
Не менее важным аспектом в лечении является соблюдение диеты. Рекомендуется полностью исключить жирную, острую, пряную и соленую пищу, а также алкоголь. Следует избегать молочных продуктов, кислых овощей и фруктов. Рацион должен быть богат белками, витаминами и микроэлементами.
Важно! Питание должно быть частым и состоять из небольших порций. Не рекомендуется принимать горизонтальное положение в течение двух часов после еды. Пища должна быть щадящей — приготовленной на пару или отварной, мелко нарезанной или перетертой.
Эзофагит кандидозный вызывает множество обсуждений среди пациентов и врачей. Многие отмечают, что симптомы, такие как боль при глотании и дискомфорт в груди, могут значительно ухудшить качество жизни. Люди делятся своим опытом, рассказывая о том, как им удалось справиться с этой проблемой. Некоторые подчеркивают важность своевременной диагностики и назначения противогрибковых препаратов, которые помогают облегчить состояние. В то же время, пациенты часто упоминают о необходимости изменения диеты и образа жизни, чтобы предотвратить рецидивы. В социальных сетях можно встретить советы по укреплению иммунной системы и рекомендации по поддержанию здоровья пищевода. Обсуждения также касаются роли стресса и других факторов, способствующих развитию заболевания. В целом, мнения людей разнообразны, но многие согласны в том, что комплексный подход к лечению и профилактике играет ключевую роль в борьбе с этой болезнью.

Методы народной медицины
Лечение с использованием народных средств и трав направлено на укрепление иммунной системы, облегчение болевых ощущений, снятие воспалительных процессов и успокоение нервной системы.
Эффективным средством является травяной сбор, который включает в себя следующие компоненты:
- Ромашка — обладает антисептическими свойствами, предотвращает распространение грибковых инфекций и блокирует развитие осложнений.
- Подорожник. Часто применяется в лечении заболеваний желудочно-кишечного тракта. Это растение способствует регенерации тканей, заживлению язв и эрозий, уменьшает воспаление, останавливает кровотечения, повышая свертываемость крови.
- Одуванчик. Способствует образованию лейкоцитов, улучшает обмен веществ и восстанавливает силы организма.
- Пастушья сумка. Обладает противовоспалительным и ранозаживляющим действием, помогает выводить токсины из организма.
- Тысячелистник. Устраняет воспаление, предотвращает нагноение, способствует заживлению эрозий, уменьшает болевые ощущения и борется с инфекцией.
- Душица. Укрепляет организм, успокаивает нервную систему и помогает справиться с бессонницей.
Поскольку микозный эзофагит сопровождается повреждением слизистой оболочки, эффективным средством является отвар семян льна. Он обволакивает стенки пищевода, защищая их от повреждений во время приема пищи. Рекомендуется пить лечебный отвар по 0,5 стакана за полчаса до еды.
Аналогичными свойствами обладает облепиховое масло. Оно восстанавливает поврежденный эпителий, способствует заживлению ран и защищает пищевод от агрессивного воздействия соляной кислоты при рефлюксе.
Кандидозный эзофагит чаще всего не является самостоятельным заболеванием, а выступает как вторичное, то есть сопутствующее другим болезням. Для предотвращения рецидивов инфекционного воспаления необходимо своевременно лечить обострения хронических заболеваний и укреплять иммунитет.
Вопрос-ответ

Что такое кандидозный эзофагит и какие его основные симптомы?
Кандидозный эзофагит — это воспаление пищевода, вызванное грибами рода Candida, чаще всего Candida albicans. Основные симптомы включают боль при глотании, затрудненное глотание, жжение в груди, а также возможные тошноту и рвоту. У некоторых пациентов может наблюдаться белый налет на слизистой оболочке рта и горла.
Каковы факторы риска развития кандидозного эзофагита?
Факторы риска включают ослабленный иммунитет (например, у людей с ВИЧ/СПИДом, диабетом или после химиотерапии), длительное применение антибиотиков, а также использование кортикостероидов. Также риск повышается у людей с заболеваниями, связанными с нарушением глотания или рефлюксом.
Как лечится кандидозный эзофагит?
Лечение кандидозного эзофагита обычно включает противогрибковые препараты, такие как флуконазол или итраконазол. Важно также устранить факторы, способствующие развитию инфекции, и поддерживать хорошую гигиену полости рта. В некоторых случаях может потребоваться дополнительная терапия для улучшения состояния иммунной системы пациента.
Советы
СОВЕТ №1
Обратитесь к врачу для точной диагностики. Эзофагит кандидозный может иметь схожие симптомы с другими заболеваниями пищевода, поэтому важно получить профессиональную оценку и назначение лечения.
СОВЕТ №2
Следите за своим питанием. Избегайте острых, кислых и слишком горячих блюд, которые могут раздражать слизистую оболочку пищевода. Включите в рацион мягкие и легко усваиваемые продукты.
СОВЕТ №3
Поддерживайте иммунную систему. Употребление витаминов, минералов и пробиотиков может помочь укрепить иммунитет и снизить риск повторного возникновения кандидозного эзофагита.
СОВЕТ №4
Избегайте самолечения. Не принимайте противогрибковые препараты без назначения врача, так как это может привести к ухудшению состояния и развитию устойчивости грибков к лечению.